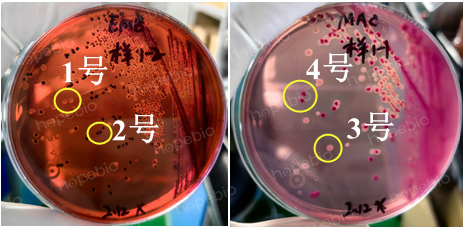
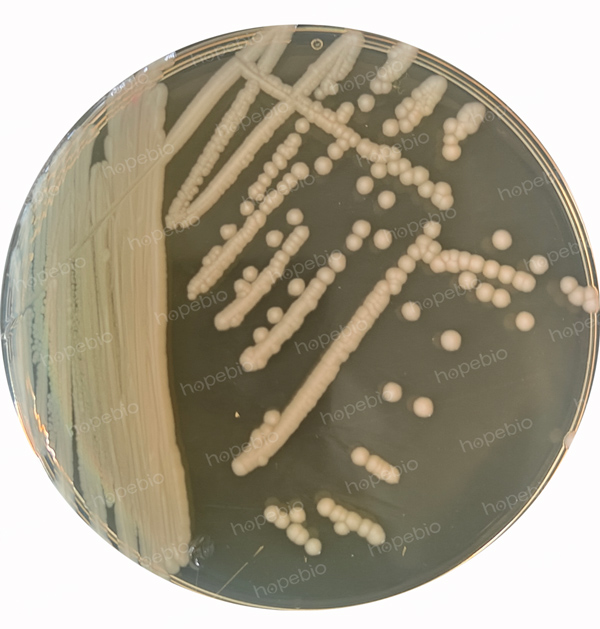

海博微信公众号
海博微信公众号
 海博天猫旗舰店
海博天猫旗舰店


 海博微信公众号
海博微信公众号
 海博天猫旗舰店
海博天猫旗舰店




一、介绍
致泻大肠埃希氏菌(Diarrheagenic Escherichia coli)是一类能够引起人类腹泻及其他胃肠道疾病的重要病原菌。作为大肠埃希氏菌(Escherichia coli)的致病性亚群,致泻大肠埃希氏菌根据其毒力因子和致病机制的不同,可分为多种类型,包括肠致病性大肠埃希氏菌(EPEC)、肠产毒性大肠埃希氏菌(ETEC)、肠侵袭性大肠埃希氏菌(EIEC)、肠出血性大肠埃希氏菌(EHEC)以及肠集聚性大肠埃希氏菌(EAEC)等。这些菌株通过污染食品、水源或接触传播,成为全球范围内食源性疾病和腹泻爆发的主要病因之一,尤其在卫生条件较差的地区,其危害更为显著。
随着全球食品贸易的快速增长和饮食习惯的多样化,食品安全问题日益受到关注。致泻大肠埃希氏菌因其广泛的传播途径和较强的致病性,成为食品安全监测的重点对象。快速、准确地检测和鉴定食品中的致泻大肠埃希氏菌,对于预防食源性疾病、保障公众健康以及维护食品安全体系具有重要意义。生化检验作为微生物检测的重要手段之一,能够通过菌株的代谢特性、酶活性等生化特征,对其进行有效鉴定和分类,为食品安全风险评估和疾病防控提供科学依据。
本文旨在探讨致泻大肠埃希氏菌的生化检验方法,分析其在实际检测中的试验方法及注意细节。
二、生化试验判别方法
致泻大肠埃希氏菌检验用生化试验分别为三糖铁琼脂(TSI)、蛋白胨水(色氨酸肉汤)、尿素琼脂(pH7.2)、氰化钾肉汤(KCN)、氧化酶试纸试验,其中氰化钾肉汤包含氰化钾试验生化管和氰化钾试验对照,生化结果判别及试验方法如表1所示。
表1 致泻大肠埃希氏菌检验用生化试验罗列
|
产品名称及货号 |
结果判别 |
培养时间(h) |
备注 |
|
|
阳性 |
阴性 |
|||
|
/ |
/ |
18-24 |
大肠埃希氏菌:斜面产酸或不产酸(黄色或红色),底层产酸(黄色) |
|
|
红色环 |
不变色或黄色 |
18-24 |
加Kovacs氏靛基质试剂2-3滴 |
|
|
红色 |
不变色或黄色 |
18-24 |
/ |
|
|
氰化钾试验生化管 |
对照和试验生化管均浑浊 |
试验生化管澄清,对照管浑浊 |
18-24 |
/ |
|
蓝色或蓝紫色 |
不显色 |
静置30s~120s |
将氧化酶试纸用蒸馏水浸湿,用细玻璃棒或一次性接种针挑取单个菌落涂在试纸上。在30 s内变为蓝色或蓝紫色为强阳性,2min内不变色为阴性。 |
|
三、生化试验检验方法及结果
本生化试验可参考食品安全国家标准《GB4789.6-2016食品微生物学检验 致泻大肠埃希氏菌检验》,6.4生化试验部分。从MAC和EMB选择平板上挑取乳糖发酵、乳糖不发酵和迟缓发酵的菌落,为分离纯化,三区划线于营养琼脂平板上,并于36℃±1℃培养18h~24h。本次示例试验从MAC和EMB上共挑取四种菌落(标记为1号~4号)进行划线分离,如图1所示,分离纯化结果应保证三区有单菌落,如图2所示,否则应继续纯化。
图1 EMB和MAC平板上的1号~4号菌落
图2 三区划线分离纯化示例
取纯化培养物于1mL-2mL生理盐水中,制备成高浓菌悬液,如图3所示。

图3 高浓菌悬液示图
取纯化培养物“之”字划线并穿刺接种于三糖铁琼脂和尿素琼脂,于36℃±1℃培养18h~24h。试验结果如图4所示。

图4 三糖铁琼脂和尿素琼脂试验结果
由图4可知,1、3号菌落TSI琼脂变黑,说明产H2S阳性,可直接判别为非大肠埃希氏菌。
同时取高浓菌悬液100μL至蛋白胨水、氰化钾肉汤、氰化钾试验对照管中,于36℃±1℃培养18h~24h。试验结果如图5所示。

1、3号试验结果相同 2、4号试验结果相同
图5 氰化钾和蛋白胨水试验结果
由图4、图5可知,2、4号菌落TSI斜面产酸(变黄)、底层产酸(变黄)、产H2S阴性(TSI琼脂不变黑),靛基质阳性(蛋白胨水滴加Kovacs氏靛基质试剂后变红)和尿素琼脂阴性(变黄),因此,基本可判别2、4号菌落为大肠埃希氏菌,为进一步验证,对其进行氧化酶试验及革兰氏染色,氧化酶试验结果阳性及革兰氏染色结果阴性,如图6所示。

图6 氧化酶试制试验及革兰氏染色结果
至此,可判别该样品中存在大肠埃希氏菌,为进一步判别致泻大肠埃希氏菌,应进行PCR确认试验。
四、HBI致泻大肠埃希氏菌生化鉴定条产品推荐
我公司产品全面,单一产品如表1所示(已附货号),为方便广大用户,还可使用“一站式”BHI致泻大肠埃希氏菌生化鉴定条,该鉴定条包含所有生化试验,货号为HBIG12-1,如图7所示。

图7 BHI致泻大肠埃希氏菌生化鉴定条
五、注意事项
1.三糖铁琼脂的配制、试验方法可参考视频“三糖铁实验操作视频”。
2.氰化钾试验的方法及注意事项可参考文章“KCN生化反应注意事项”。
3.氧化酶试纸试验方法可参考视频“氧化酶实验”。
注:本文属海博生物原创,未经允许不得转载。
下一篇:没有了!



